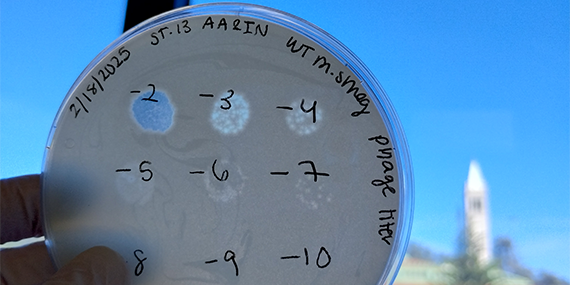
Plaque assay testing different titers of bacteriophage in wild-type Mycobacterium smegmatis

|
Save the Date | MCB Alumni & Friends JP Morgan Reception |
YOUR GIFT MAKES A DIFFERENCE! |
|
What have you been up to lately? |
Want to receive the online newsletter in your inbox? |
Connect With Us!
CREDITS
| MCB Transcript is published twice a year by the Department of Molecular & Cell Biology at the University of California, Berkeley. |
| WRITING: Kirsten Mickelwait |
| MANAGING EDITOR: Tanya Sullivan |
| EDITOR: Héctor L. Torres Vera |
| ONLINE PRODUCTION: Tanya Sullivan |
| PHOTO CREDITS: Masthead Image: Galaxea fascicularis coral (Cleves Lab); iBio 2025 (Camryn Zurita); MCB Alumni & Friends reception (Johnny Gan Chong) |
| MCB Newsletter |
| University of California |
| Molecular and Cell Biology Department |
| 142 Weill Hall #3200 |
| Berkeley, CA 94720-3200 |
| Send Address Changes to: |
| University Development and Alumni Relations |
| 2080 Addison St #4200 |
| Berkeley, CA 94720-4200 |
| Or e-mail: transcript@mcb.berkeley.edu |